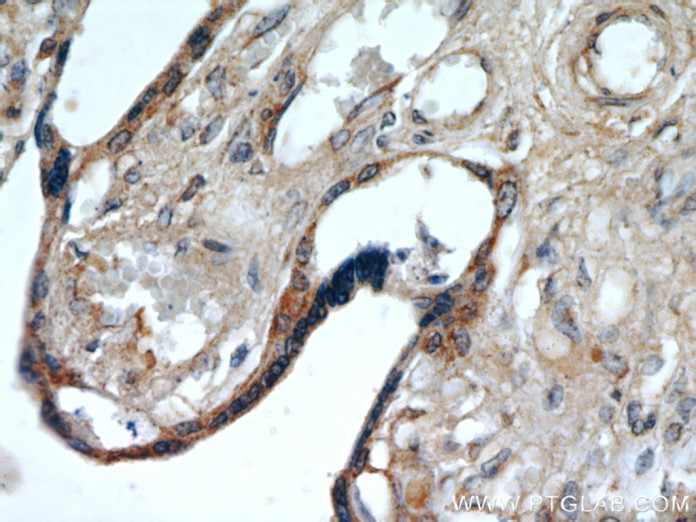

PLAC8, una proteína que hasta ahora ha sido poco entendido, parece jugar un papel clave en la difusión – o metástasis – de cáncer colorrectal o cáncer de colon.
 La investigación anterior ha encontrado que PLAC8 está relacionado con el cáncer de colon. Ahora, en un nuevo estudio publicado en la revista Journal of Clinical Investigation , los investigadores de la Escuela de Medicina de St. Louis, MO , y la Universidad de Vanderbilt Medical Center en Nashville, TN, la Universidad de Washington revelan que la proteína activa a las células normales que revisten el colon al cambio en un estado que ayuda a cáncer de colon a extenderse.
La investigación anterior ha encontrado que PLAC8 está relacionado con el cáncer de colon. Ahora, en un nuevo estudio publicado en la revista Journal of Clinical Investigation , los investigadores de la Escuela de Medicina de St. Louis, MO , y la Universidad de Vanderbilt Medical Center en Nashville, TN, la Universidad de Washington revelan que la proteína activa a las células normales que revisten el colon al cambio en un estado que ayuda a cáncer de colon a extenderse.
Co-autor Lilianna Solnica-Krezel , profesor y jefe del Departamento de Biología del Desarrollo de Washington, dice:
«Sabíamos que los niveles de esta proteína son elevados en el cáncer de colon Ahora que hemos demostrado lo PLAC8 podría estar haciendo – . Haciendo que las células de la transición a un estado que permite que se propaguen «.
La investigación, que implica el estudio de la proteína en el pez cebra , se inició en un laboratorio en la Universidad de Vanderbilt y luego se trasladó a la Universidad de Washington.
Vanderbilt es también donde el autor principal, Robert Coffey, el profesor Ingram de Investigación del Cáncer , y su grupo han estado desarrollando formas de crecimiento de las células de cáncer de colon en tres dimensiones en lugar de la cultura plato plano de dos dimensiones más convencional.
Cuando se las arreglaron para lograr que las células de cáncer de colon a crecer en tres dimensiones , el grupo encontró que crecieron en una de dos formas : o bien las bolas huecas o mechones puntiagudos con los bits puntiagudas que sobresalen en sus alrededores.
Entonces, al inyectar estos dos tipos de células de cáncer de colon en ratones , encontraron las matas espinosas forman tumores que se propagan con mayor rapidez .
Demasiado PLAC8 causa embriones de pez cebra para desarrollar de forma anormal
Cuando el equipo comparó las firmas genéticas de los dos tipos de células de cáncer en tres dimensiones , encontraron las matas espinosas , que formaron los tumores más agresivos , tenían mucho más altos niveles de expresión de PLAC8 .
Aquí es donde el pez cebra vienen pulg Ellos son un modelo ideal de laboratorio – por ejemplo, que son versátiles , pequeño y fácil de criar – para el estudio de muchos de los procesos biológicos que son comunes en todas las especies de vertebrados. En este caso , el equipo que utiliza para estudiar PLAC8 para ver exactamente cómo influye en los diferentes tipos de células y tejidos, como explica el profesor Solnica – Krezel :
«Nos fijamos en esta proteína en el pez cebra y vimos que también se expresa en el intestino. En el pez cebra normal, PLAC8 está presente en el revestimiento interno del intestino. También hay que destacar PLAC8 está fuertemente expresado en los primeros embriones de pez cebra. »
El equipo también encontró que cuando hay demasiado PLAC8 , los embriones de pez cebra se desarrollan anormalmente – las células se mueven más lentamente que resulta en formas corporales anormales y otros defectos .







